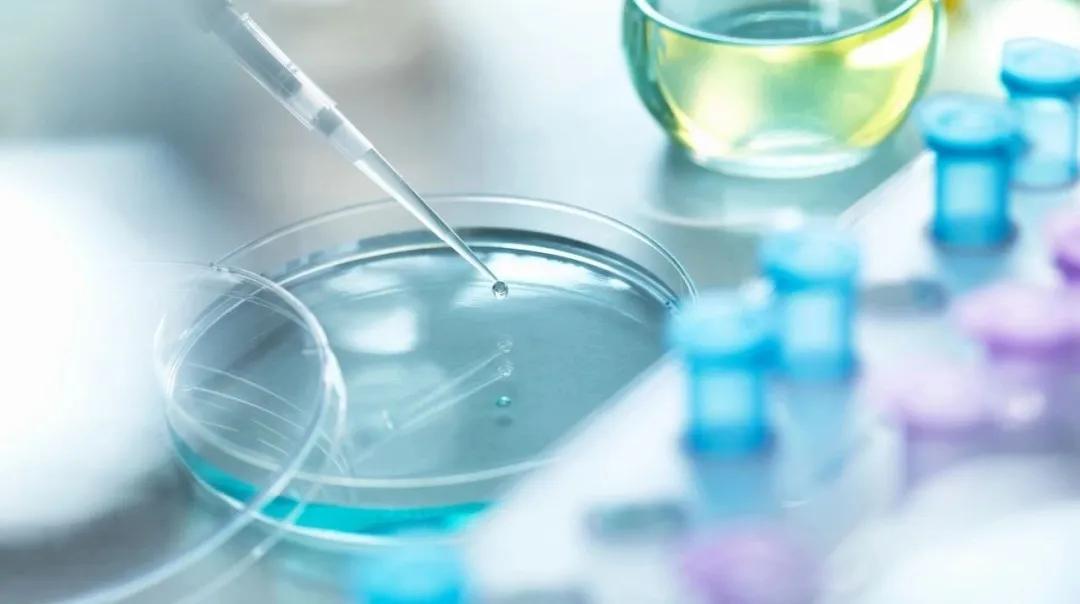
Image

PCT和CRP,在诊断细菌感染时哪一个更好?
发布时间:2024-09-18
在临床实践中,准确诊断细菌感染对于及时采取有效治疗措施至关重要。降钙素原(PCT)和C反应蛋白(CRP)是两种常用的生物标志物,它们在诊断细菌感染方面各有优势和局限性。
PCT是由甲状腺C细胞分泌的前体物质 ,在健康人体内浓度极低。当发生全身性细菌感染时,PCT水平会迅速升高。这一特性使得PCT成为诊断细菌感染,尤其是脓毒症的有力工具。研究表明, PCT在诊断细菌感染时具有较高的特异性和灵敏度 。当PCT水平超过0.5 ng/mL时,可以作为细菌感染的有力证据。更重要的是,PCT水平与感染的严重程度呈正相关,这使得它在评估患者病情和指导治疗方面具有独特优势。
相比之下, CRP是一种急性时相反应蛋白 ,主要由肝脏在炎症刺激下产生。CRP在多种炎症状态下都会升高,包括细菌感染、病毒感染和非感染性炎症。这使得CRP在区分细菌感染和其他炎症状态时特异性较差。然而,CRP的优势在于其升高速度快,通常在感染后6-12小时就能检测到显著升高。因此,CRP在早期诊断和监测炎症反应方面具有重要价值。
在实际应用中,单独依赖PCT或CRP都可能造成误诊或漏诊。因此,越来越多的临床医生倾向于联合检测PCT和CRP。研究表明, 当PCT>0.5 ng/mL且CRP>10 μg/mL时,诊断细菌感染的灵敏度可达97.72% ,特异性为83.08%,准确度为82.67%。这种联合检测方法不仅能提高诊断准确性,还能帮助医生更全面地评估患者状况。
值得注意的是,PCT和CRP在不同类型的细菌感染中表现各异。例如,在革兰阴性菌感染中,PCT水平通常高于革兰阳性菌感染。这提示我们,在解读检测结果时,还需要结合临床表现和其他实验室检查。
尽管PCT和CRP在诊断细菌感染方面表现出色,但它们并非完美无缺。例如, PCT在某些非感染性炎症状态下也可能升高 ,如严重创伤和烧伤。而CRP则可能在病毒感染时也出现升高。因此,在使用这些标志物时,医生需要结合临床表现和其他检查结果进行综合判断。
总的来说,PCT和CRP各有优势,联合检测可以为临床医生提供更全面的信息。然而,它们都不能完全替代细致的临床评估和必要的微生物学检查。在诊断细菌感染时,医生应该将这些生物标志物视为辅助工具,而不是唯一的诊断依据。只有将实验室检查与临床表现相结合,才能做出最准确的诊断,为患者提供最佳的治疗方案。